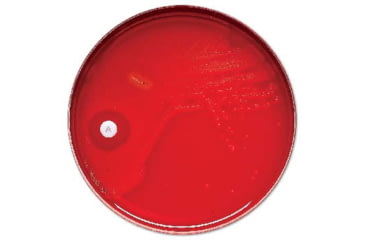
Image of BD Antibiotics and AntimycoticsNorfloxacin to Vancomycin, BD Diagnostics 231047 Taxo P Disks
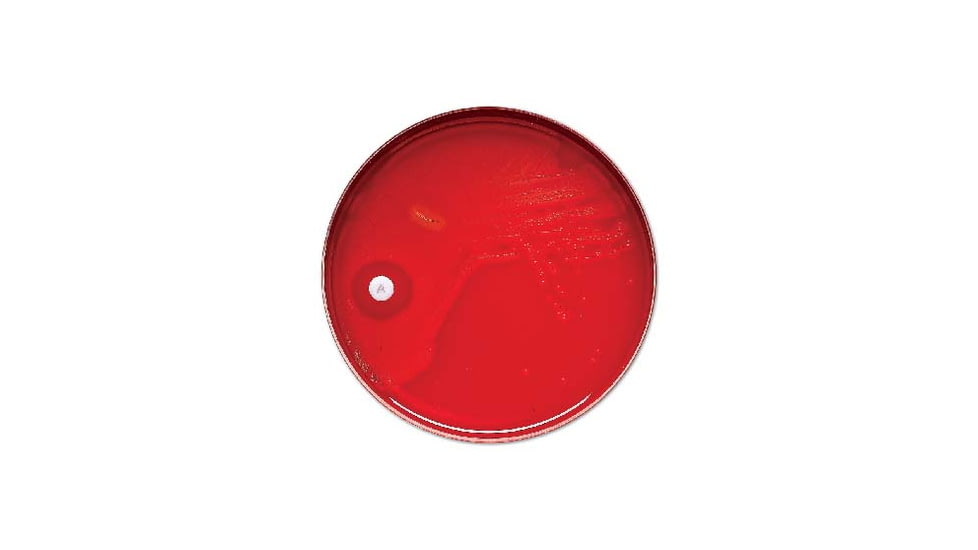
BD Antibiotics and AntimycoticsNorfloxacin to Vancomycin, BD Diagnostics 231047 Taxo P Disks

Tap Tap to Zoom
Code: B4-9NH-231047
MPN: 231047
Product Info for BD Antibiotics and AntimycoticsNorfloxacin to Vancomycin, BD Diagnostics 231047 Taxo P Disks
BD Antibiotics and AntimycoticsNorfloxacin to Vancomycin, BD Diagnostics Taxo P Disks is a reliable and dependable addition to the BD Laboratory Media family of products. Combining top-notch and uncompromising quality with an affordable price, the BD Antibiotics and AntimycoticsNorfloxacin to Vancomycin, BD Diagnostics Taxo P Disks 231047/ 90002-128 can fulfill your laboratory needs while still offering a great value for the money.![]()
Product Category Description:
This collection of media products is used for the qualitative susceptibility testing of mycobacteria and related organisms. These items provide a reliable, convenient, and rapid method for the evaluation of susceptibility of microorganisms to anti-microbial agents.
Ordering Information: Each test includes 50 susceptibility disks per catridge.
Specifications for BD Antibiotics and AntimycoticsNorfloxacin to Vancomycin, BD Diagnostics 231047 Taxo P Disks:
| Description: | Taxo P Disks | |
| BD No.: | 231047 | |